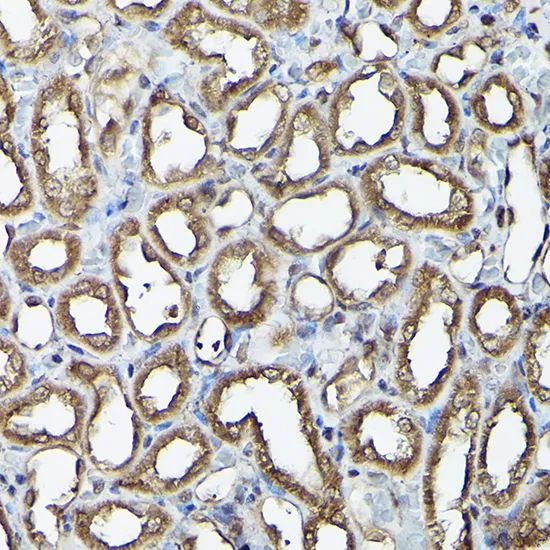

WB analysis of various sample lysates using GTX30079 Ataxin 3 antibody. Dilution : 1:1000 Loading : 25microg per lane
Ataxin 3 antibody
GTX30079
ApplicationsImmunoFluorescence, Western Blot, ImmunoCytoChemistry, ImmunoHistoChemistry, ImmunoHistoChemistry Paraffin
Product group Antibodies
TargetATXN3
Overview
- SupplierGeneTex
- Product NameAtaxin 3 antibody
- Delivery Days Customer7
- Application Supplier NoteWB: 1:500 - 1:2000. ICC/IF: 1:50 - 1:200. IHC-P: 1:50 - 1:200. *Optimal dilutions/concentrations should be determined by the researcher.Not tested in other applications.
- ApplicationsImmunoFluorescence, Western Blot, ImmunoCytoChemistry, ImmunoHistoChemistry, ImmunoHistoChemistry Paraffin
- CertificationResearch Use Only
- ClonalityPolyclonal
- ConjugateUnconjugated
- Gene ID4287
- Target nameATXN3
- Target descriptionataxin 3
- Target synonymsAT3, ATX3, JOS, MJD, MJD1, SCA3, ataxin-3, Machado-Joseph disease protein 1, josephin, olivopontocerebellar ataxia 3, spinocerebellar ataxia type 3 protein
- HostRabbit
- IsotypeIgG
- Protein IDP54252
- Protein NameAtaxin-3
- Scientific DescriptionMachado-Joseph disease, also known as spinocerebellar ataxia-3, is an autosomal dominant neurologic disorder. The protein encoded by this gene contains (CAG)n repeats in the coding region, and the expansion of these repeats from the normal 12-44 to 52-86 is one cause of Machado-Joseph disease. There is a negative correlation between the age of onset and CAG repeat numbers. Alternatively spliced transcript variants encoding different isoforms have been described for this gene. [provided by RefSeq, Jul 2016]
- Storage Instruction-20°C or -80°C,2°C to 8°C
- UNSPSC12352203